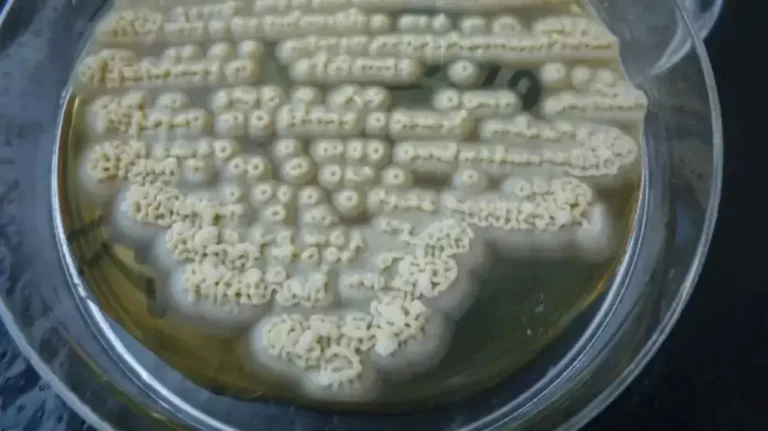

Sustrato para el cultivo de hongos; Formulaciones
Introducción al cultivo de hongos En el vasto y fascinante mundo…

Introducción al cultivo de hongos En el vasto y fascinante mundo…
¡Bienvenidos a nuestra completa guía sobre el apasionante mundo del cultivo…

Desentrañando el Misterio de los Hongos y sus Estrategias Reproductivas Los…

Introducción a los hongos Morel Los hongos Morel, una joya escondida…

En el vasto reino de los microorganismos, los mohos destacan por…
Definición de levaduras Las levaduras son microorganismos unicelulares que pertenecen al…

En un nuevo estudio, el científico Andrew Adamatzky, informático de la…

Que son los endofitos? Los hongos endófitos son una categoría fascinante…

Investigadores del Instituto de Botánica de Kunming de la Academia China…

Las orellanas son uno de los hongos más agresivos y fáciles…